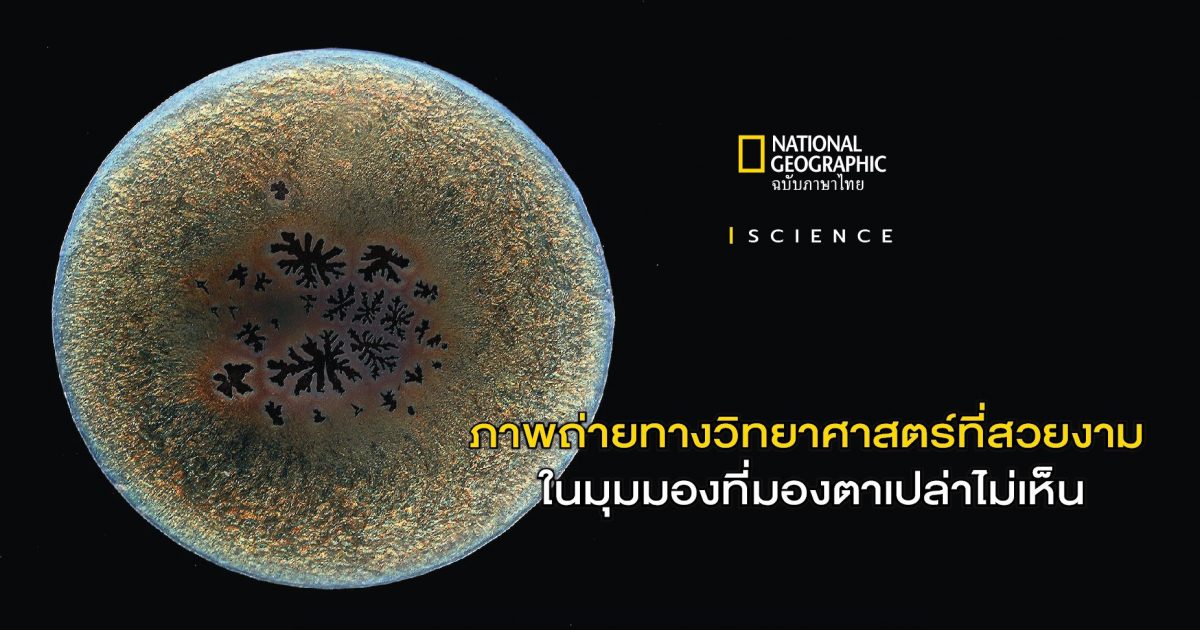

ภาพถ่ายทางวิทยาศาสตร์ ที่จะพาคุณไปชมสีสันสดใสแห่งธรรมชาติสรรค์สร้างอันน่าตื่นตะลึง ที่ตาเปล่าของเราไม่อาจมองเห็น
เราต่างรู้ว่า กฎพื้นฐานทางฟิสิกส์, การค้นพบครั้งสำคัญในเชิงชีววิทยา และแนวคิดวิทยาศาสตร์ต่างๆ นั้นซับซ้อน แต่สามารถนำมาประยุกต์ใช้ได้ในชีวิตประจำวันได้
ทว่า นักวิทยาศาสตร์จะทำให้งานของพวกเขา และความคิดเหล่านั้นเป็นที่เข้าใจได้กับคนทั่วไปได้อย่างไร คำตอบอาจจะอยู่ที่ เฟลิซ แฟรงเคิล
แฟรงเคิล ประจำอยู่ที่สถาบันเทคโนโลยีแมสซาชูเซตส์ หรือเอ็มไอที (Massachusetts Institute of Technology-MIT) เธอได้ช่วยนักศึกษามากมายหาหนทาง “ฉายภาพ” ความคิดของพวกเขาออกมา หนังสือของเธอที่ชื่อว่า ภาพถ่ายวิทยาศาสตร์และวิศวกรรม (Picturing Science and Engineering) เต็มไปด้วยตัวอย่างของงานวิจัยและข้อมูลที่เธอได้แปลงออกมาเป็นภาพถ่ายที่น่าอัศจรรย์ โดยแฟรงเคิลได้กล่าวถึงประเด็นสำคัญว่า ภาพเหล่านี้ช่วยบรรดานักวิทยาศาสตร์ “เข้าใจความสวยงามของภาพซึ่งทำให้สาธารณชนเข้าถึงงานของพวกเขาได้”
การถ่ายภาพแบบนี้ไม่ต้องใช้อุปกรณ์พิเศษอะไรมากมาย ในหนังสือ เธอกล่าวว่าใช้เพียงแค่ เครื่องสแกนแบบแท่นเรียบ (Flatbed Scanner) ซึ่งสามารถควบคุมความคมชัดได้ แม้จะเป็นอุปกรณ์ที่ไม่ได้ทันสมัยมากนัก แต่ก็ช่วยให้เกิดภาพที่ให้รายละเอียดข้อมูลของสิ่งของชนิดต่างๆ ตั้งแต่หินอาเกต ไปจนถึงหอยเป๋าฮื้อ
“มันมหัศจรรย์มากๆ เป็นรายละเอียดที่ไม่สามารถมองเห็นได้ด้วยตาเปล่าเลยค่ะ” แฟรงเคิลกล่าว โดยเครื่องสแกนแท่นเรียบนี้สามารถจับภาพวัตถุที่มีโครงสร้างซับซ้อน ตั้งแต่จานเพาะเชื้อไปจนถึงเครื่องมือที่ใช้วิเคราะห์ประเภทต่างๆ แล้วนำเสนอออกมาในรูปแบบใหม่ๆ














ภาพ FELICE FRANKEL